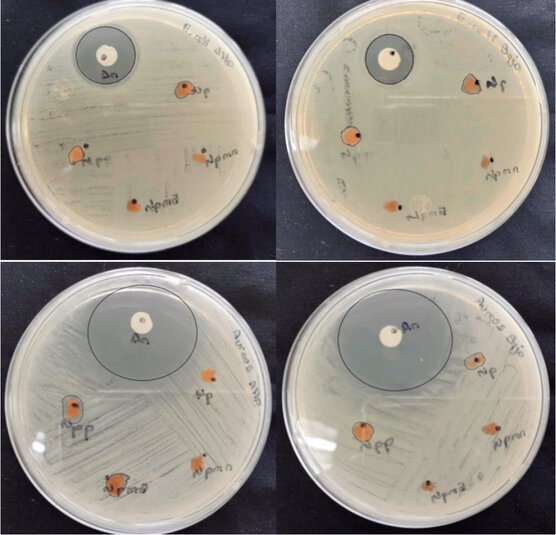

Innovative encapsulation for enhanced drug delivery using stingless bee propolis and honey Tetragonisca angustula (Hymenoptera: Meliponini), and their antimicrobial activity
Diego Otuna-Hernández 1,2, Alexandra D. Hernández Hernández 2, Leslie Espinoza-Castro 1,
Lilian M. Spencer 1, Hortensia Rodríguez ,3,*
1 School of Biological Sciences and Engineering, Yachay Tech University, Urcuquí 100119, Ecuador; diego.otuna@yachaytech.edu.ec; alehernandez2301@gmail.com; leslie.espinosa@yachaytech.edu.ec, lspencer@yachaytech.edu.ec.
2 Instituto Nacional de Biodiversidad (INABIO), Quito 170501, Ecuador.
3 Yachay Tech Medicinal Chemistry Research Group (MedChem-YT), School of Chemical Science and Engineering, Yachay Tech University, Urcuqui 100119;
* Correspondence: hmrodriguez@yachaytech.edu.ec
Lilian M. Spencer 1, Hortensia Rodríguez ,3,*
1 School of Biological Sciences and Engineering, Yachay Tech University, Urcuquí 100119, Ecuador; diego.otuna@yachaytech.edu.ec; alehernandez2301@gmail.com; leslie.espinosa@yachaytech.edu.ec, lspencer@yachaytech.edu.ec.
2 Instituto Nacional de Biodiversidad (INABIO), Quito 170501, Ecuador.
3 Yachay Tech Medicinal Chemistry Research Group (MedChem-YT), School of Chemical Science and Engineering, Yachay Tech University, Urcuqui 100119;
* Correspondence: hmrodriguez@yachaytech.edu.ec
ABSTRACT
Propolis, known for its immunological and therapeutic properties due to flavonoids and phenolic acids, has been used in alternative medicine for many years. In Ecuador, the commercialization of stingless bee honey has been increasing recently, although the physical-chemical and biological characteristics of honey from each species are unknown due to their different behaviors and diets. The objective of this research was to synthesize chitosan nanoparticles by encapsulating commercial honey (NPMC), honey (NPMA), and propolis (NPP) from Tetragonisca angustula by ionic gelation and glutaraldehyde cross-linking. The polymeric nanoparticles were structurally characterized (TGA and FT-IR), and their antimicrobial activity against E. coli and S. aureus, cytotoxicity, and controlled release were evaluated in two phases at different pH levels, one gastric (pH 1.8) and intestinal (pH 7.4). FT-IR analysis of the polymeric nanoparticles revealed the presence of hydroxyl and alkyl groups. NPMA and NPP showed characteristic vibrations of flavonoids and C=O, regardless of the molecular weight of chitosan. In the TGA, the NPMC had decomposition efficiencies of 97.22% (LMW) and 92.10% (HMW). Propolis nanoparticles achieved encapsulation efficiencies of 94.31% and 89.21%. NPPA (HMW-chitosan-based nanoparticles encapsulating propolis from stingless bees) was the most effective against S. aureus. NPPB (LMW-chitosan-based nanoparticles encapsulating propolis from stingless bees) at 10 μg/mL showed higher cytotoxicity than NPMAA (HMW-chitosan-based nanoparticles encapsulating honey from stingless bees). In summary, propolis nanoparticles maintained efficiencies above 76%, while NPMC and NPMA exhibited loading capacities greater than 27%. In contrast, formulations with high molecular weight chitosan showed slightly lower values, although these differences were not statistically significant.
Keywords: Tetragonisca angustula, stingless bee; polymeric nanoparticles; controlled released; antimicrobial activity
INTRODUCTION
Bees, with more than 20,000 species identified globally, are critical for pollination, an essential process for sustaining life on land 1 . The family Apidae, in particular, the stingless bee tribe Meliponini, play a crucial role in tropical and subtropical ecosystems 2 . The Apis mellifera species is known for its efficiency in honey production, but it is essential to highlight the importance of native species such as Tetragonisca angustula for their ecological functions and highly beneficial products 3 . This species can be found only in Latin America, from Mexico to northern Argentina 4,5 . In Ecuador, there are many information gaps about the total number and distribution of stingless bee species. However, several researchers specializing in tropical bees have recorded this species and have developed several studies evidencing the importance of its conservation in different ecosystems 6 . Meliponiculture emerges as a sustainable practice that benefits the conservation of stingless bees 7 . Besides, pollination by these species is vital for 30% to 80% of plants in their biomes, highlighting their importance in the conservation of fauna and flora communities 8 . The morphological features of Tetragonisca angustula are presented in Figure 1, supporting its identification and distribution in Latin America. Its honey is prized for its unique flavor and health benefits, and is commonly used in respiratory and eye treatments in communities 9 . The propolis of this species stands out for its antimicrobial properties, attributed to flavonoids 9 . These products are of great interest to the population of the Amazon region because they have low humidity and therapeutic potential 10 .
Nanotechnology has become an important alternative for the stabilization of applications, ranging from proteins to drug delivery. 11 Their versatility and nanometer size make them excellent candidates for a variety of applications, including drug discovery, water purification, imaging, and others 12 . Methods such as ionic gelation and microemulsion are commonly used for its synthesis, offering a promising approach for drug delivery and other biomedical applications 13 . Conversely, chitosan is a versatile and biodegradable polysaccharide with unique properties 14,15 . Modulating deacetylation and its molecular weight significantly influence its physical and biological properties 16,17 . Chitosan nanoparticles offer a safe and effective way of drug delivery, as they allow for controlled loading of drugs due to their amino and hydroxyl groups 18 . Drug delivery systems are crucial to improving therapeutic efficacy and minimizing side effects 19 . The combination of drug delivery systems with natural products offers a promising strategy for the treatment of chronic diseases such as cancer, taking advantage of the biocompatible and non-toxic properties of these materials 20 . Finally, antimicrobial activity requires an essential criterion of antibacterial susceptibility testing; normally, the strains used to perform these tests are E. coli and S. aureus 21 .
Herein, this study aimed to synthesize, characterize, and test the antimicrobial activity of LMW and HMW-chitosan-based nanoparticles (NPQ) encapsulating commercial honey (NPMC), stingless bee propolis (NPP), and honey (NPMA) Tetragonisca angustula (Hymenoptera: Meliponini). Both spectroscopies (Fourier Transformed Infrared FT-IR, and Thermogravimetric analysis TGA) were applied for structural characterization of nanoparticles. Likewise, antimicrobial activity against two strains of E. coli and S. aureus, cytotoxicity using a standard Roche protocol, and controlled release simulating two phases at different pH, one gastric (pH=1.8) and intestinal (pH=7.4) were examined. The outcomes may provide a novel design, improved stability, and biocompatibility of propolis Tetragonisca angustula bioactive compounds during processing, with potential biomedical applications.

Figure 1. Tetragonisca angustula. Scientific illustration of the stingless bee species studied, native to Latin America and valued for its honey and propolis with medicinal properties. (Tetragonisca angustula illustration by Alexandra D. Hernández Hernández., 2024)
MATERIAL AND METHODS
Materials
Propolis and stingless bee honey Tetragonisca angustula (Hymenoptera: Meliponini) were obtained directly from a meliponary (Puyo, Ecuador). Chitosan (low and high molecular weight), acetic acid (1%), arabic gum (0.3%), glutaraldehyde (1%), and all other chemicals were acquired at the Laboratory of Chemical Sciences and Engineering, and Biological Sciences and Engineering of Yachay Tech University, respectively (Urcuquí, Ecuador).
Equipment
Fourier transform infrared spectroscopy (FT-IR) was performed on a Cary 630 FT-IR spectrometer; the analysis was performed with the method (Attenuated total reflection). Thermogravimetric analysis (TGA) was carried out on a TGA-1000/1500 using a small microfurnace with a small scanning volume. ThermoFisher ScientificTM Company Heratherm IMP-180 refrigerated incubator, ThermoFisher ScientificTM Company Nanodrop Uv-Vis spectrophotometer, and Telstar AV-30/70 vertical laminar flow cabinet were used to perform biological essays. Finally, drug delivery release was performed using a ThermoFisher ScientificTM Company pH meter, a ThermoFisher ScientificTM Company AccuSpin 24C centrifuge, and a Thermo ScientificTM TX-400 4 x 400 ml tiltable rotor (75003180).
Extraction of the propolis
Propolis was extracted using 70% ethanol by the maceration method 22 . The ratio of solvent and propolis was 10:1 (v/w). First of all, 10 g of propolis was vigorously mixed with 100 mL of 70% ethanol for 10 minutes at room temperature, 25°C. This mixture was left to rest for 24 hours at room temperature in a stirrer with a speed of 120 rpm. It was then vacuum-filtered through filter paper. The filtrate was then concentrated using a rotary steamer at 40°C at 120 rpm (Stirring plate) to remove the solvent ethanol. Finally, 3.6 g of concentrate was obtained and stored at room temperature.
Preparation of chitosan-based nanoparticles encapsulating honey and propolis extract
15mL of chitosan solution (0.7%) was prepared by dissolving the chitosan powder in acetic acid (1%) under continuous stirring for one hour. 7.5 mL arabic gum (0.3%) solution was prepared in ionized type I water at room temperature, to which 1.5 mL of propolis extract Tetragonisca angustula (Hymenoptera: Meliponini) (25%) was added gradually, by vigorous agitation, until a homogeneous mixture was achieved. Arabic gum/propolis extract mixture was added to the chitosan solution, and then 7.5 mL of glutaraldehyde (1%) was injected as a cross-linking agent by syringe, under continuous agitation, for two hours, thus allowing the formation of nanoparticles. For FT-IR, TGA, and biological activity measurements, the nanoparticles were super-frozen (-80°C), then lyophilized, and finally stored at room temperature until characterization and biological assays. The same procedure was used to make the different nanoparticles of commercial honey and stingless bee honey Tetragonisca angustula (Hymenoptera: Meliponini) of LMW and HMW-chitosan, respectively.
Structural characterization
Polymeric nanoparticles were investigated by FT-IR (Fourier Transformed Infrared Spectroscopy) in the range 4000-900 cm-1, using the Agilent Cary 630 FT-IR spectrometer, which used an ATR system. TGA (Thermogravimetric analysis) was performed with a Q500 instrument. The nanoparticle samples (approximately 5.0 ± 2.0 mg) were placed on a standard platinum palette. The scan was performed at a rate of 10 °C/min under a nitrogen flux, and the change in mass from 25 °C to 700 °C was recorded.
Antimicrobial activity
The strains used to evaluate antimicrobial activity were Escherichia coli ATCC 25922 and Staphylococcus aureus ECBI-UITEY through the Kirby-Bauer disk diffusion susceptibility test on Mueller-Hinton (MH) agar medium 23 . Reserve bacterial cultures were incubated for 12 hours at 37°C and 120 rpm in a sterile Luria Bertani broth base (LB). Lyophilized nanoparticle samples to be tested were prepared in a circular form using a press. All samples were made with a weight of 0.6 mg at a concentration of 0.16 μg/mL. The nanoparticles were neither diluted nor filtered to avoid loss; they were only hydrated with previously autoclaved Type I water. Once this process was completed, each MH agar plates were seeded with bacterial strains (E. coli ATCC 25922 and S. aureus ECBI-UITEY) whose turbidity was adjusted to the 0.5 McFarland standard. The inoculated plates were then incubated at 37 °C for 24 hours. After this period, the inhibition zones were observed. Ampicillin (1 mg/mL) and chitosan-based nanoparticles of HMW and LMW were used as positive control and blank, respectively.
MTT colorimetric assay for cytotoxicity
The standard protocol of Roche Corporation for colorimetric cell proliferation assays 24 was employed to assess the cytotoxicity of the nanoparticle samples. These samples were previously treated, meaning that initially a concentration of 1 mg/mL was obtained, and subsequently, they were diluted to achieve concentrations of 10 μg/mL and 100 μg/mL, respectively. On the other hand, the 3T3 fibroblast cell culture was prepared in advance. Cell line was harvested using a cell scraper, and cell viability was assessed by staining with trypan blue in a Neubauer chamber. Dulbecco's Modified Eagle Medium (DMEM) supplemented with 1% antibiotics and 10% heat-inactivated fetal bovine serum (FBS) was used, and this medium was prepared in two different concentrations, both 1x and 4x. Culture medium was added to the 96-well microplates for cell culture. First, 50 μL of 1x medium was added, followed by 50 μL of 4x medium, then 50 μL of each previously diluted nanoparticle sample (10 μg/mL and 100 μg/mL, respectively), and finally 50 μL of cells. Finally, the microplate was incubated at 37 ºC for 72 hours with 5% CO2. Subsequently, 20 μL of the MTT reagent was added to each well and incubated for 4 hours at 37 °C in a humidified chamber. During this incubation, absorbance was measured at 630 nm with the microplate reader at 0 hours, 4 hours, and 4 hours + buffer.
Encapsulation efficiency, loading capacity, and controlled release
The encapsulation efficiency of the nanoparticles was assessed through a filtration procedure as follows: the nanoparticles were separated from free propolis in the mixture using a membrane filter (PVDF Millex filter unit), and the amount of free propolis in the filtrate was measured spectrophotometrically at 450 nm. Encapsulation efficiency (EE%) and loading capacity (LC%) of the propolis extract in the nanoparticles were determined using the following equations:

Where:
Ct corresponds to the total amount of propolis used in the loading stage.
Cf denotes the amount of free propolis in the filtrate.
Cd represents the amount of propolis present in the nanoparticles after the freeze-drying process.
Cumulative release of propolis was investigated in simulated gastrointestinal solutions with pH=1.8 and pH=7.4. Simulated solutions were prepared according to the literature 25, 26 as follows:
Simulated Gastric Fluid (SGF), an artificial medium designed to simulate stomach acid, was prepared by dissolving 0.66 g of sodium chloride and 1.06 g of purified pepsin (derived from the stomach mucosa of pigs) in 2.32 mL of hydrochloric acid and water, reaching a total volume of 95.96 mL. The final solution was adjusted to a pH of 1.8.
Simulated Intestinal Fluid (SIF), was prepared by dissolving 0.31 g of monobasic potassium phosphate in 25 mL of water. Subsequently, 7.7 mL of 0.2 N sodium hydroxide and 50 mL of water were added. Then, 0.45 g of pancreatin was added, and the resulting solution was adjusted with 0.2 N hydrochloric acid to a pH of 7.4. Finally, the solution was diluted to a total volume of 100 mL.
0.23 g of lyophilized polymeric nanoparticles encapsulating propolis/honey was used, and they were dispersed in the two previously simulated fluids. The release rate was also determined by dividing the gastric phases (0-180 minutes) and small intestinal phases (180-300 minutes), respectively. However, the solution containing released propolis must be centrifuged at 3000 rpm for 10 minutes because propolis is insoluble in water; subsequently, the sedimented propolis was spectrophotometrically measured at 300 nm. Finally, the concentration of released propolis was calculated using a standard absorption curve. Moreover, the percentage of released propolis was calculated using the following equation:

Where:
CPr stands for the concentration of released propolis after a specific time interval.
CPt denotes the total amount of propolis encapsulated in the nanoparticles.
Statistical analysis
Data normality was used before further analysis was performed. Shapiro-Wilk and Kruskal-Wallis H-test (for non-parametric variables) were used to test the level of significance in the differences between chitosan-based nanoparticle samples in the cytotoxicity and drug delivery assays. Statistical analysis was performed using IMB SPSS Statistics for Windows version 22.0.
RESULTS
Polymer nanoparticles were synthesized and chemically characterized using FT-IR, HPLC, and TGA. The synthesis was carried out as described in Chapter 2, resulting in eight samples of chitosan-based nanoparticles (with low and high molecular weight) encapsulated with honey and propolis, respectively. All synthesized nanoparticles underwent a freeze-drying process after being frozen in a super-freezer to facilitate chemical testing and biological assays.
Characterization of chitosan-based nanoparticles
The structure of polymeric nanoparticles was corroborated by TGA and FT-IR spectroscopy. Structural characterization of powdered chitosan-based nanoparticles (NPQ) encapsulating commercial honey (NPMC), stingless propolis (NPP), and honey (NPMA) Tetragonisca angustula was using low molecular weight (LMW) chitosan-based nanoparticles and secondly using high molecular weight chitosan. For example, Figure 2 shows the chitosan-based nanoparticles with LMW spectrum, with the presence of the distinctive band of the flavonoids and lipids (C=O), aromatic rings (C-H), and polyols (C-O, C-OH) groups around 1700 cm-1, 1463cm-1, and 1032 cm-1 respectively, attributed to phosphate groups and proteins, but also the broad characteristics bands of the hydroxyl (OH), and alkyl (C-H) groups at around 3351 cm-1, and 2936 cm-1. On the other hand, Figure 3 shows the chitosan-based nanoparticles with the HMW spectrum. Nevertheless, this spectrum shows one additional group attributed to the presence of chitosan HMW, corresponding to a symmetrical stretch (C-O-C) at around 1155 cm-1, which was also observed.

Figure 2. FT-IR spectrum of low molecular weight (LMW) chitosan nanoparticles encapsulating honey and propolis from T. angustula. Characteristic bands of flavonoids, lipids, and hydroxyl groups confirm the incorporation of phenolic compounds into the polymeric matrix.

Figure 3. FT-IR spectrum of high molecular weight (HMW) chitosan nanoparticles. An additional signal corresponding to a symmetrical stretch (C–O–C) is observed, attributed to the HMW chitosan structure, highlighting structural differences compared to LMW formulations.
Related to TGA, all analyzed nanoparticle samples showed decomposition similarities. Each experiment was divided into three main groups. Loss of water and chitosan compounds, degradation of chitosan, commercial, stingless bee honey and propolis, and Organic impurities and polymer network decomposition around 50-175°C, 176-300°C, and 500-700°C, respectively (Figures 4 and 5). Based on the data provided, the decomposition of LMW and HMW chitosan-based nanoparticles encapsulating stingless honey (NPMA) exhibits the highest decomposition efficiency, registering 97% for LMW and 92% for HMW. Second, stingless bee propolis (NPP) exhibits high decomposition, reaching 94% for LMW and 89% for HMW. Finally, HMW chitosan-based nanoparticles (NPQ) show relatively lower decomposition at 77%.

Figure 4. Thermogravimetric analysis (TGA) of low molecular weight chitosan nanoparticles. Three main degradation phases are identified: water loss and volatile compounds (50–175 °C), chitosan and phenolic compounds degradation (176–300 °C), and polymer network decomposition (500–700 °C).

Figure 5. Thermogravimetric analysis (TGA) of high molecular weight chitosan nanoparticles. The profile shows greater thermal stability compared to LMW formulations, reflecting the formation of a denser polymeric network.
Antimicrobial activity analysis
Related to antimicrobial activity, the chitosan-based nanoparticles encapsulating stingless bee propolis (NPP) showed good inhibitory activity against Gram-positive bacteria and low activity against Gram-negative bacteria, as shown in Figure 5 and Table 1. S. aureus was more susceptible to all the tested nanoparticle samples, maintaining the same concentration (0.16 μg/mL). Regarding the bactericidal properties of stingless honey, a halo of 0.70 mm was observed. Importantly, this halo occurs specifically in the S. aureus ECBI-UITEY strain and not in E. coli ATCC 25922. This difference is explained by the gram-positive nature of the S. aureus ECBI-UITEY strain, which makes it more susceptible to the bactericidal action of stingless honey. In contrast, gram-negative bacteria, such as E. coli ATCC 25922, possess an outer cell membrane that makes them more resistant to these effects 27 .
Figure 6. In vitro antimicrobial activity of nanoparticles at 0.16 μg/mL against Gram-positive (S. aureus) and Gram-negative (E. coli) bacteria. Inhibition zones demonstrate greater susceptibility of S. aureus to the encapsulated compounds.

Table 1. Antimicrobial activity of chitosan nanoparticles encapsulating honey and propolis from T. angustula against S. aureus (Gram-positive) and E. coli (Gram-negative). Inhibition zone diameters (mm ± SD) were evaluated at 0.16 μg/mL using the disk diffusion assay.
Cytotoxicity assay analysis
In this study, the cytotoxicity of the various polymeric nanoparticles was evaluated at concentrations of 10 and 100 μg/mL, respectively. The results were recorded at 630 nm using 96-well microplates for a cell culture reader at three time points: at time zero, after four hours, and after four hours with the buffer. The four-hour measurement was previously selected because it is the time needed for the reaction to fully develop, thus ensuring optimal measurement, as illustrated in Figure 7. To assess possible significant differences, a one-way analysis of variance (P> 0.05) was applied. The data associated with the 10 μg/mL concentration are parametric in nature, revealing that there are no significant differences between nanoparticles encapsulated with commercial honey, stingless bee propolis, and honey, compared to the control. Similarly, it is observed that nanoparticles at concentrations of 100 μg/mL do not generate harmful effects, since the Kruskal-Wallis statistical analysis did not reveal significant differences between the nanoparticles and the control.

Figure 7. Cytotoxicity (MTT) assay of nanoparticles at 10 and 100 μg/mL on 3T3 fibroblasts. Absorbance values at 630 nm were recorded after four hours of incubation. No significant differences with the control were observed, confirming the biocompatibility of the formulations.
Encapsulation efficiency and loading capacity
Encapsulation efficacy (EE%) and loading capacity (LC%) of propolis extract and stingless honey in a chitosan matrix reinforced with arabic gum and cross-linked with glutaraldehyde were calculated according to ratios (2.1) and (2.2) previously described in the Methodology. Importantly, the trial was conducted in triplicate. The EE% and LC% results for two different pH phases are presented in Table 2. It is observed that chitosan-based nanoparticles encapsulated with propolis show encapsulation efficiencies greater than 76% under both simulations. Additionally, it is intriguing to note that the encapsulation efficiency (EE%) for the LMW-chitosan-based nanoparticles encapsulated in stingless honey is similar in both phases. Regarding loading capacities, nanoparticles encapsulated with stingless bee propolis exhibit higher values, exceeding 29% in both conditions. Notably, LMW-chitosan-based nanoparticles, both encapsulating commercial honey and stingless bee honey, show good loading capacities, exceeding 27%.

Figure 8. Encapsulation efficiency (EE%) and loading capacity (LC%) of chitosan nanoparticles loaded with honey and propolis from T. angustula in simulated gastric (pH 1.8) and intestinal (pH 7.4) fluids. Results indicate higher retention and controlled release for propolis compared to honey.

Table 2. Encapsulation efficiency (EE%) and loading capacity (LC%) of chitosan nanoparticles loaded with honey and propolis from T. angustula in simulated gastric fluid (SGF, pH 1.8) and simulated intestinal fluid (SIF, pH 7.4). Propolis-loaded nanoparticles achieved the highest EE% and LC% values under both conditions.
In vitro drug delivery release
The results of the determination of the encapsulation concentrations of the natural products used in this study are detailed in Figures 9, 10, and 11, respectively. It is noted that the best encapsulations are achieved with LMW-chitosan. Despite the nature of commercial honey, FGS with LMW-chitosan is observed to reach 0.09 mg/mL encapsulation, while FIS with the same chitosan variant reaches 0.15 mg/mL. Nevertheless, there was a loss of 16% in FGS and 12% in FIS, with an improvement of 4% for FIS compared to FGS, both using low molecular weight chitosan. This loss could be associated with commercial residues of honey in synthesis or freeze-drying.

Figure 9. Encapsulated concentrations of commercial honey in simulated gastric (SGF) and intestinal (SIF) fluids, measured at 290 nm. A higher loss is observed in the gastric phase, associated with honey crystallization.
In contrast, Figure 10 shows the results of the concentration of chitosan nanoparticles encapsulated with stingless honey. Compared to commercial honey, significant differences are observed: in FGS, the encapsulation concentration reaches 0.16 mg/mL, while in FIS, 0.17 mg/mL is recorded. Nonetheless, in the concentrations of stingless honey encapsulations, there is evidence of a lower loss of natural product compared to commercial honey, around 12% for FGS, while in FIS there is a loss of 8%. This variation is associated with the crystallization of commercial honey, while stingless honey remains stable due to its acidity.

Figure 10. Encapsulated concentrations of T. angustula honey in simulated gastric (SGF) and intestinal (SIF) fluids, measured at 270 nm. Lower losses compared to commercial honey are evident due to the acidic stability of stingless bee honey.

Figure 11. Encapsulated concentrations of T. angustula propolis in simulated gastric (SGF) and intestinal (SIF) fluids, measured at 330 nm. Nanoparticles show the highest encapsulation efficiency and the lowest loss of the natural product.
The release profiles of the products encapsulated in the nanoparticles, as a function of incubation time in FGS (pH=1.8), and FIS (pH=7.4), were calculated according to the ratio (2,3) described earlier in Methodology. The results of these calculations are presented in Figure 12. Chitosan and arabic gum nanoparticles can efficiently retain loaded products in the gastric medium. In other words, in an acidic environment after 180 minutes, the release profile of stingless bee propolis indicates that there is a release of 36% of LMW-chitosan/Arabic gum polymer matrix compared to a 32% release of the same compound, but with HMW. In other words, 11% more release is observed between propolis with different molecular weights of chitosan. After five hours, values of 63% were obtained for LMW-chitosan propolis, while HMW-chitosan recorded 51%. These results indicate the presence of a strong polymer network that prevented the loss of propolis. In addition, it is highlighted that oral carriers require a slow release in the gastric phase [25] . Regarding the release profile of commercial honey, a value of 44% is observed in both LMW chitosan and HMW chitosan. This indicates that commercial honey faces greater difficulties in its release, possibly due to its composition and the immediate formation of crystals. Conversely, both commercial honey and stingless honey show a difference of 3%, a minimal variation that could be attributed to their acidity and virtually no crystal formation 28 . Finally, between propolis and honey of the same species, there is a difference of 5%, while with commercial honey, there is a significant disparity of 20% in terms of release 29 . The Kruskal-Wallis statistical test did not reveal significant differences (P > 0.05) in the medians of the groups, and the data in each group show an approximately normal distribution.

Figure 12. Cumulative release profiles of LMW and HMW chitosan nanoparticles loaded with commercial honey, stingless bee honey, and propolis from T. angustula in simulated gastric and intestinal fluids. Results demonstrate gradual release in acidic medium and sustained release in intestinal medium.
DISCUSSION
Effective strategies for the drug delivery of bioactive components, such as propolis, have gained significant relevance in the field of pharmaceuticals 10 . Although the therapeutic potential of these components has been demonstrated, the efficacy of their application is limited by challenges in the controlled release and stability of the compounds 30 . Consequently, the present work addresses the synthesis and characterization of low and high-molecular-weight chitosan nanoparticles that encapsulate commercial honey and stingless bee propolis Tetragonisca angustula. The products of this species contain antimicrobial and anti-cancer properties due to the pollination of native Amazonian plants with purely medicinal properties. 9 . In addition, antimicrobial efficacy, controlled release, and cytotoxicity between encapsulated and unencapsulated nanoparticles are compared. In a previous study,3 remarkable physicochemical properties and the successful encapsulation efficiency of a chitosan nanoparticle encapsulated with propolis obtained from Romania were evaluated.
Characterization techniques (FT-IR and TGA) allowed us to reaffirm the structures of the polymeric nanoparticles, identifying the most representative functional groups with signals. On the other hand, despite measurements in a concentration range of 10 to 100 μg/mL, no relevant peaks were observed during characterization in the UHPLC analysis. This can be attributed to the previous filtration of the nanoparticles with a filter size of 0.22 μm.
It is noteworthy that the high molecular weight chitosan nanoparticle encapsulated with stingless bee propolis exhibited the highest inhibition, especially against the S. aureus ECBI-UITEY strain, followed by the E. coli strain ATCC 25922. These results are consistent with previous studies, such as 33,34 , which showed the antimicrobial activity of propolis in specific strains. In addition, 35 conclusions support the results by noting the efficacy of propolis against Gram-positive and Gram-negative bacteria, highlighting that this efficacy varies depending on the chemical composition of propolis. As for the other four inhibition halos recorded in this research, three are associated with chitosan nanoparticles, both high and low molecular weight, and one with nanoparticles encapsulated with stingless bee honey. Chitosan's antimicrobial efficacy has been consistently supported by several studies that have evidenced its activity in the formation of HMW and LMW nanoparticles 36–38 .
As far as the cytotoxicity assay is concerned, there are no significant differences between the various polymer nanoparticle encapsulations and the control at concentrations of 10 or 100 μg/mL, suggesting that none of the polymeric nanoparticles are harmful at these concentrations 39 . Nevertheless, it is noteworthy that both HMW and LMW-chitosan-based nanoparticles, encapsulating propolis, and those encapsulating stingless bee honey, show high optical densities. Specifically, nanoparticles encapsulated with propolis exhibit the highest optical density at both concentrations 40 . In contrast, LMW-chitosan-based nanoparticles have the lowest optical density at both concentrations, which is consistent with studies suggesting that encapsulating a compound, whether natural or man-made, in chitosan enhances its properties 41,42 .
Propolis release profiles plotted as a function of incubation time in FGS (pH=1.8) and FIS (pH=7.4). It can be deduced that polymeric nanoparticles strongly retain encapsulated natural products, in this case, propolis charged in a gastric environment. After 180 minutes in an acidic medium, the release profile showed a release of 36% of stingless bee propolis for the low molecular weight chitosan matrix, compared to 32% for the high molecular weight matrix. Nonetheless, previous studies 31 , show an 18% release from the chitosan/arabic gum matrix. On the other hand, after transferring the particles to a basic medium, after 300 minutes, release values of 63% were obtained for propolis with low molecular weight chitosan and 51% for high molecular weight, indicating a strong polymeric network that prevents the loss of propolis and a controlled release in the intestinal environment. In this phase, in previous studies, 25, 3 , 55% of propolis was released from the matrix.
The robust biopolymer network is considered to inhibit the escape of propolis, and a gradual release into the stomach is highly desirable for use as an oral vehicle. This release process can be attributed to the possible swelling of the polymeric matrix in an acidic environment, resulting from flavonoids and protonation of the amino groups of chitosan.
In our CS-PVP systems with propolis from Tetragonisca angustula, the encapsulation efficiency (EE) remained high (≥76%) and reached up to ~94% (LMW) and ~89% (HMW), with controlled release that favored the intestinal over the gastric medium (e.g., LMW: 63% vs. 36% at 300 min; HMW: 51% vs. 37%). These values are in the upper range of those reported for nano/microencapsulation of propolis from other bee species and botanical sources. For example, Egyptian propolis (Apis mellifera) encapsulated in alginate nanoparticles achieved EE of 84.6–95.9% with good stability and antimicrobial activity 44 ,45 , while chitosan-coated liposomes loaded with stingless bee propolis from Southeast Asia showed EE ≈90% and improved resistance to degradation, resulting in sustained release under physiological conditions 46,47 . Protein-based systems, such as zein/CMCS nanoparticles with Chinese propolis, reported EE ~83% and gradual release profiles 48–50 . By contrast, hydrogel-like matrices obtained by coacervation (chitosan–pectin) with Brazilian propolis showed lower EE (≈19–38%) and a strong dependence on the release medium (distilled water vs. artificial saliva), highlighting how the carrier architecture and the surrounding environment strongly influence both retention and release kinetics 51–53 . Overall, our EE values and the higher release fraction under intestinal conditions align with the best-performing polymeric systems reported for Apis mellifera and stingless bees, suggesting that the CS-PVP combination enhances both the retention of phenolic compounds from propolis and their targeted delivery to the intestine 50,52,54,55 .
Differences among studies also reflect the chemical diversity of propolis depending on bee species and local flora. Resins rich in artepillin C (green propolis from Apis mellifera in Brazil or Taiwan) tend to show high affinity for cationic matrices (e.g., chitosan) and protein/hydrophobic cores (e.g., zein), supporting high EE and pH-dependent release 50,52,55 . In stingless bees from various regions of the world (e.g., Tetragonula/Heterotrigona and T. angustula), the higher proportion of terpenoids and flavonoids with varied polarity may enhance hydrophobic and electrostatic interactions with CS-PVP or with chitosan-coated liposomes, explaining EE values comparable or superior to those of Apis mellifera and release profiles more pronounced in intestinal medium 46,47,52,55 . This general pattern, high EE (≳80–90%) and release favored at near-neutral pH, appears consistently in well-designed polymeric and liposomal carriers, whereas less densely cross-linked formulations or softly coacervated systems tend to sacrifice EE and exhibit faster, more medium-dependent release51–53 .
CONCLUSIONS
The preparation and characterization of polymeric nanoparticles of natural products based on chitosan/arabic gum, which encapsulate commercial honey, propolis, and honey from native stingless bees Tetragonsica angustula (Hymenoptera: Meliponini), was achieved. The physicochemical properties of these nanoparticles were evaluated by FT-IR and TGA spectroscopy. An efficient encapsulation procedure was implemented using glutaraldehyde as the cross-linking agent. FT-IR analysis revealed that the characteristic bands of propolis were maintained during mixing, indicating that bioactive components, such as flavonoids, were stable during the encapsulation process. On the other hand, the TGA analysis showed that the nature and composition of these components influence the thermal properties of the nanoparticles, and that the molecular weight of chitosan plays a crucial role in their degradation profile. The antimicrobial activity of propolis was evidenced in this study, showing variable effectiveness depending on the strain and concentration. Notably, propolis-encapsulated chitosan/arabic gum nanoparticles (NPPA) were highly effective against S. aureus ECBI-UITEY. Besides, no significant differences in cytotoxicity were observed between the various encapsulations and the control, suggesting the safety of these polymeric nanoparticles at the concentrations evaluated. In this innovative formulation, a proper balance in electrostatic interaction was achieved, which contributes to its effectiveness as a controlled release vehicle. The results of propolis release into simulated gastric and intestinal fluids indicate that this formulation is suitable for pharmaceutical applications, offering greater stability and bioavailability of bioactive compounds, specifically propolis, along with additional nutritional value.
Author Contributions: Conceptualization, D.O. and H.R.; Methodology, D.O., H. R., and L.S..; validation, D.O., L.E. and A.H.; formal analysis, X.X.; investigation, D.O., L.E. and A.H.; data curation, A.H.; writing—original draft preparation, D.O. and H.R.; writing—review and editing, H.R.; supervision, H.R. and L.S.; project administration, H.R. and L.S. All authors have read and agreed to the published version of the manuscript.
Funding: This research received no external funding.
Institutional Review Board Statement: Not applicable.
Informed Consent Statement: Not applicable.
Acknowledgments: The authors thank the support from the Yachay Tech Internal Project (CHEM-25-01), and we acknowledge the Meliponiculture and Beekeeping Association of the Province of Pastaza, Ecuador; particularly Corina Cajas and Oscar Campos, for their valuable collaboration in the conservation of native bees.
Conflicts of Interest: The authors declare no conflict of interest.
REFERENCES
1. Villalobos J HM, Córdova A L V, Perú L, Espinosa E EA, Guanoluisa R CE, Villacís YJ. Impact of bees (Apis mellifera L.) as Pollinating Agents in the Performance of the Zucchini Crop (Cucurbita pepo L.) in the Canton Riobamba, Province of Chimborazo. Vol. 15. 2019.
2. Michener C. The Bees of the World. 2nd ed. 2007.
3. González J, Quezada J. Biodiversidad y Desarrollo Humano en Yucatán I Uso de la Flora y Fauna Silvestre [Internet]. 2016 [cited 2024 May 1]. Available from: https://www.cicy.mx/documentos/cicy/sitios/biodiversidad/pdfs/cap7/19%20produccion%20tradicional%20de%20miel.pdf
4. Paulo S. Variabilidade genética de Tetragonisca angustula (Hymenoptera, Apidae, Meliponini) de meliponários. Genetic variability of Tetragonisca angustula (Hymenoptera, Apidae, Meliponini) from meliponaries. 2013.
5. Rojas DG. Diversidad morfológica y genética de Tetragonisca angustula (Hymenoptera: Apidae) en Cundinamarca, Colombia. 2022.
6. Bravo E. La biodiversidad en el Ecuador. Abya-Yala. Quito; 2014.
7. Nates-Parra G. Neotropical Braconidae Wasps-233 Campos Biota Colombiana. Vol. 2, Biota Colombiana. 2001.
8. Kerr JT. Butterfly Species Richness Patterns in Canada: Energy, Heterogeneity, and the Potential Consequences of Climate Change [Internet]. Vol. 5, Ecology. 2001. Available from: http://www.npwrc.usgs.gov/resource/distr/lepid/bflyusa/bflyusa.htm
9. Manrique AJ, Santana WC. Flavonoides, actividades antibacteriana y antioxidante de propóleos de abejas sin aguijón, Melipona quadrifasciata, Melipona compressipes, Tetragonisca angustula y Nannotrigona sp. de Brasil y Venezuela. Vol. 26, Zootecnia Trop. 2008.
10. Vit P, González I, Sorroza L, Pedro RMS. Caracterización físicoquímica de miel de angelita Tetragonisca angustula (Latreille, 1811) producida en Esmeraldas, Ecuador. Revista Ciencia UNEMI [Internet]. 2016 [cited 2024 May 1];9(20):77–84. Available from: https://www.redalyc.org/articulo.oa?id=582663826011
11. Galindo-Pérez M, Morales-Ibarría M, Reyes-Duarte D, Hernández-Arana A, Campos-Terán J, Arroyo-Maya I. NANOPARTÍCULAS DE C-FICOCIANINA: AUTOENSAMBLADO, ACTIVIDAD ANTIOXIDANTE Y ESTUDIOS DE ESTABILIDAD. Vol. 2023, Año.
12. Stark WJ. Nanoparticles in biological systems. Vol. 50, Angewandte Chemie - International Edition. 2011. p. 1242–58.
13. Mohammed MA, Syeda JTM, Wasan KM, Wasan EK. An overview of chitosan nanoparticles and its application in non-parenteral drug delivery. Vol. 9, Pharmaceutics. MDPI AG; 2017.
14. Jafernik K, Ładniak A, Blicharska E, Czarnek K, Ekiert H, Wiącek AE, et al. Chitosan-Based Nanoparticles as Effective Drug Delivery Systems—A review. Vol. 28, Molecules. MDPI; 2023.
15. Rashki S, Asgarpour K, Tarrahimofrad H, Hashemipour M, Ebrahimi MS, Fathizadeh H, et al. Chitosan-based nanoparticles against bacterial infections. Vol. 251, Carbohydrate Polymers. Elsevier Ltd; 2021.
16. Liu SH, Chiu CY, Shi CM, Chiang MT. Functional comparison of high and low molecular weight chitosan on lipid metabolism and signals in high-fat diet-fed rats. Mar Drugs. 2018 Jul 30;16(8).
17. Wang W, Meng Q, Li Q, Liu J, Zhou M, Jin Z, et al. Chitosan derivatives and their application in biomedicine. Vol. 21, International Journal of Molecular Sciences. MDPI AG; 2020.
18. Kono H, Kato T. Elucidation of substituent distribution states for carboxymethyl chitosan by detailed NMR analysis. Carbohydrate Polymer Technologies and Applications. 2021 Dec 25;2.
19. Mansour A, Romani M, Acharya AB, Rahman B, Verron E, Badran Z. Drug Delivery Systems in Regenerative Medicine: An Updated Review. Vol. 15, Pharmaceutics. MDPI; 2023.
20. Garg U, Chauhan S, Nagaich U, Jain N. Current advances in chitosan nanoparticles based drug delivery and targeting. Vol. 9, Advanced Pharmaceutical Bulletin. Tabriz University of Medical Sciences; 2019. p. 195–204.
21. Temmerman R, Garmyn A, Antonissen G, Vanantwerpen G, Vanrobaeys M, Haesebrouck F, et al. Evaluation of fluoroquinolone resistance in clinical avian pathogenic escherichia coli isolates from flanders (Belgium). Antibiotics. 2020 Nov 1;9(11):1–14.
22. Kong YT, Abdullah V, Mokhtar SU, Kutty RV. Preliminary studies on extraction of propolis using vitamin E d-α-Tocopheryl polyethylene glycol succinate (vitamin E TPGS) and compare their antimicrobial activities. Malays J Microbiol. 2020;16(5):346–52.
23. Hudzicki Jan. Kirby-Bauer Disk Diffusion Susceptibility Test Protocol [Internet]. 2009. Available from: www.atcc.org
24. Sigma-Aldrich. Cell Proliferation Kit I (MTT) [Internet]. 2020 [cited 2023 Oct 8]. Available from: https://www.sigmaaldrich.com/deepweb/assets/sigmaaldrich/product/ documents/191/466/11465007001.pdf
25. Cavalu S, Prokisch J, Laslo V, Vicas S. Preparation, structural characterisation and release study of novel hybrid microspheres entrapping nanoselenium, produced by green synthesis. IET Nanobiotechnol. 2017 Jun 1;11(4):426–32.
26. Jayakumar R, Reis RL, Mano JF. Synthesis and characterization of pH-sensitive thiol-containing chitosan beads for controlled drug delivery applications. Drug Deliv. 2007 Jan 1;14(1):9–17.
27. Ceballos S, Lozano C, Aspiroz C, Ruiz-Ripa L, Eguizábal P, Campaña-Burguet A, et al. Beyond CC398: Characterisation of Other Tetracycline and Methicillin-Resistant Staphylococcus aureus Genetic Lineages Circulating in Spanish Hospitals. Pathogens. 2022 Mar 1;11(3).
28. Macario Melitón Fierro Martínez. Ecología de Tetragonisca angustula (Apidae, Meliponini): comunicación de recursos y áreas de congregación de zánganos. 2011.
29. Kuen CY, Masarudin MJ. Chitosan Nanoparticle-Based System: A New Insight into the Promising Controlled Release System for Lung Cancer Treatment. Vol. 27, Molecules. MDPI; 2022.
30. Magnavacca A, Sangiovanni E, Racagni G, Dell’Agli M. The antiviral and immunomodulatory activities of propolis: An update and future perspectives for respiratory diseases. Vol. 42, Medicinal Research Reviews. John Wiley and Sons Inc; 2022. p. 897–945.
31. Cavalu S, Bisboaca S, Mates IM, Pasca PM, Laslo V, Costea T, et al. Novel Formulation Based on Chitosan-Arabic Gum Nanoparticles Entrapping Propolis Extract Production, physico-chemical and structural characterization [Internet]. Available from: http://www.revistadechimie.ro
32. Matos BN, Lima AL, Cardoso CO, Cunha-Filho M, Gratieri T, Gelfuso GM. Follicle-Targeted Delivery of Betamethasone and Minoxidil Co-Entrapped in Polymeric and Lipid Nanoparticles for Topical Alopecia Areata Treatment. Pharmaceuticals. 2023 Sep 1;16(9).
33. Vică ML, Glevitzky M, Heghedűş-Mîndru RC, Dumitrel GA, Heghedűş-Mîndru G, Popa M, et al. Phyto-Inhibitory and Antimicrobial Activity of Brown Propolis from Romania. Antibiotics. 2023 Jun 1;12(6).
34. Torres AR, Sandjo LP, Friedemann MT, Tomazzoli MM, Maraschin M, Mello CF, et al. Chemical characterization, antioxidant and antimicrobial activity of propolis obtained from melipona quadrifasciata quadrifasciata and tetragonisca angustula stingless bees. Brazilian Journal of Medical and Biological Research. 2018;51(6).
35. Przybyłek I, Karpiński TM. Antibacterial properties of propolis. Vol. 24, Molecules. MDPI AG; 2019.
36. Yilmaz Atay H. Antibacterial activity of chitosan-based systems. In: Functional Chitosan: Drug Delivery and Biomedical Applications. Springer Singapore; 2020. p. 457–89.
37. Kravanja G, Primožič M, Knez Ž, Leitgeb M. Chitosan-based (Nano)materials for Novel Biomedical Applications. Vol. 24, Molecules. MDPI AG; 2019.
38. Divya K, Vijayan S, George TK, Jisha MS. Antimicrobial properties of chitosan nanoparticles: Mode of action and factors affecting activity. Fibers and Polymers. 2017 Feb 1;18(2):221–30.
39. Aibani N, Rai R, Patel P, Cuddihy G, Wasan EK. Chitosan nanoparticles at the biological interface: implications for drug delivery. Vol. 13, Pharmaceutics. MDPI; 2021.
40. Ortiz M, Rodríguez H, Lucci E, Coro J, Pernía B, Montero-Calderon A, et al. Serological Cross-Reaction between Six Thiadiazine by Indirect ELISA Test and Their Antimicrobial Activity. Methods Protoc. 2023 Apr 1;6(2).
41. Sarangapani S, Patil A, Ngeow YK, Elsa Mohan R, Asundi A, Lang MJ. Chitosan nanoparticles' functionality as redox active drugs through cytotoxicity, radical scavenging and cellular behaviour. Integrative Biology (United Kingdom). 2018 May 1;10(5):313–24.
42. Sonin D, Pochkaeva E, Zhuravskii S, Postnov V, Korolev D, Vasina L, et al. Biological safety and biodistribution of chitosan nanoparticles. Nanomaterials. 2020 Apr 1;10(4).
43. Cardoso MJ, Costa RR, Mano JF. Marine origin polysaccharides in drug delivery systems. Vol. 14, Marine Drugs. MDPI AG; 2016.
44. Sukri N, Putri TTM, Mahani, Nurhadi B. Characteristics of propolis encapsulated with gelatin and sodium alginate by complex coacervation method. Int J Food Prop [Internet]. 2023 Sep 22 [cited 2025 Aug 24];26(1):696–707. Available from: https://www.tandfonline.com/doi/pdf/10.1080/10942912.2023.2179635
45. Amrane S, Chaalal M, Bouriche S, Ydjedd S, Rezgui F, Amessis-Ouchemoukh N, et al. Optimisation of microencapsulation efficiency of propolis phenolic compounds by double emulsion method using response surface methodology. Acta Aliment [Internet]. 2024 Mar 11 [cited 2025 Aug 24];53(1):34–47. Available from: https://doi.org/10.1556/066.2023.00244
46. Saroglu O, Karadag A. Propolis-loaded liposomes: characterization and evaluation of the in vitro bioaccessibility of phenolic compounds. ADMET DMPK [Internet]. 2024 [cited 2025 Aug 24];12(1):209–24. Available from: https://doi.org/10.5599/admet.2204
47. Ramli NA, Ali N, Hamzah S, Yatim NI. Physicochemical characteristics of liposome encapsulation of stingless bees' propolis. Heliyon [Internet]. 2021 Apr 1 [cited 2025 Aug 24];7(4). Available from: https://doi.org/10.1016/j.heliyon.2021.e06649
48. Jansen-Alves C, Victoria FN, Borges CD, Zambiazi RC. Encapsulation of propolis extract in ovalbumin protein particles: characterization and in vitro digestion. Nat Prod Res [Internet]. 2024 [cited 2025 Aug 24];38(10):1766–70. Available from: https://doi.org/10.1080/14786419.2023.2214945
49. Jansen-Alves C, Fernandes KF, Crizel-Cardozo MM, Krumreich FD, Borges CD, Zambiazi RC. Microencapsulation of Propolis in Protein Matrix Using Spray Drying for Application in Food Systems. Food Bioproc Tech [Internet]. 2018 Jul 1 [cited 2025 Aug 24];11(7):1422–36. Available from: https://doi.org/10.1007/s11947-018-2115-4
50. Zhang H, Fu Y, Xu Y, Niu F, Li Z, Ba C, et al. One-step assembly of zein/caseinate/alginate nanoparticles for encapsulation and improved bioaccessibility of propolis. Food Funct [Internet]. 2019 Feb 20 [cited 2025 Aug 24];10(2):635–45. Available from: https://pubs.rsc.org/en/content/articlehtml/2019/fo/c8fo01614c
51. Nori MP, Favaro-Trindade CS, Matias de Alencar S, Thomazini M, de Camargo Balieiro JC, Contreras Castillo CJ. Microencapsulation of propolis extract by complex coacervation. Lwt - Food Science and Technology [Internet]. 2011 [cited 2025 Aug 24];44(2):429–35. Available from: https://doi.org/10.1016/J.LWT.2010.09.010
52. Cea-Pavez I, Manteca-Bautista D, Morillo-Gomar A, Quirantes-Piné R, Quiles JL. Influence of the Encapsulating Agent on the Bioaccessibility of Phenolic Compounds from Microencapsulated Propolis Extract during In Vitro Gastrointestinal Digestion. Foods [Internet]. 2024 Feb 1 [cited 2025 Aug 24];13(3). Available from: https://doi.org/10.3390/foods13030425
53. Salehi A, Rezaei A, Damavandi MS, Kharazmi MS, Jafari SM. Almond gum-sodium caseinate complexes for loading propolis extract: Characterization, antibacterial activity, release, and in-vitro cytotoxicity. Food Chem [Internet]. 2023 Mar 30 [cited 2025 Aug 24];405:134801. Available from: https://www.sciencedirect.com/science/article/abs/pii/S0308814622027637?via%3Dihub
54. Shakoury N, Aliyari MA, Salami M, Emam-Djomeh Z, Vardhanabhuti B, Moosavi-Movahedi AA. Encapsulation of propolis extract in whey protein nanoparticles. LWT [Internet]. 2022 Mar 15 [cited 2025 Aug 24];158:113138. Available from: https://www.sciencedirect.com/science/article/pii/S0023643822000731?via%3Dihub
55. Spanidi E, Karapetsas A, Voulgaridou GP, Letsiou S, Aligiannis N, Tsochantaridis I, et al. A New Controlled Release System for Propolis Polyphenols and Its Biochemical Activity for Skin Applications. Plants [Internet]. 2021 Feb 1 [cited 2025 Aug 24];10(2):1–27. Available from: https://doi.org/10.3390/plants10020420
Received: June 25, 2025 / Accepted: August 25, 2025 / Published: September 15, 2025
Citation: Otuna-Hernández D, Hernández A, Espinoza-Castro L, Spencer LM, Rodríguez H. Innovative encapsulation for enhanced drug delivery using stingless bee propolis and honey Tetragonisca angustula (Hymenoptera: Meliponini), and their antimicrobial activity.. Bionatura Journal 2025;2(3):10. doi: 10.70099/BJ/2025.02.03.10
Additional information: Correspondence should be addressed to hmrodriguez@yachaytech.edu.ec
Peer review information. Bionatura thanks anonymous reviewer(s) for their contribution to the peer review of this work using https://reviewerlocator.webofscience.com/
ISSN.3020-7886
All articles published by Bionatura Journal are made freely and permanently accessible online immediately upon publication, without subscription charges or registration barriers.
Publisher's Note: Bionatura Journal stays neutral concerning jurisdictional claims in published maps and institutional affiliations.
Copyright: © 2025 by the authors. They were submitted for possible open-access publication under the terms and conditions of the Creative Commons Attribution (CC BY) license (https://creativecommons.org/licenses/by/4.0/).




